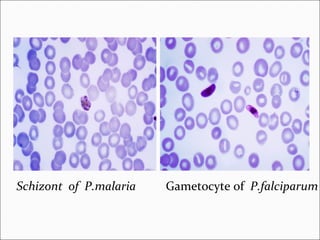
Schizont of P.malaria Gametocyte of P.falciparum

The document summarizes information about Plasmodium species that cause malaria in humans. It discusses the four main species that infect humans - P. falciparum, P. vivax, P. malariae, and P. ovale. It describes their life cycles, which involve development in both human and mosquito hosts. Symptoms in humans include febrile paroxysms and potential complications like cerebral malaria, blackwater fever, and anemia. Diagnosis involves examining blood smears microscopically to identify the parasite stages. Rapid diagnostic tests and quantitative buffy coat analysis can also be used. Treatment depends on the species but may include chloroquine, quinine, and primaquine.